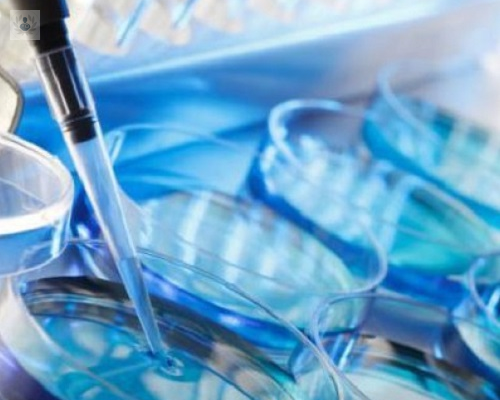
congelacion-de-ovulos-proceso

Congelación de óvulos: Una alternativa futura para lograr un embarazo
La congelación de óvulos no garantiza el logro de un embarazo en el futuro, ya que esto depende de muchos factores como la edad, el número y calidad de los óvulos y otras condiciones médicas. Sin embargo, es una alternativa posible para postergar unos años la maternidad.